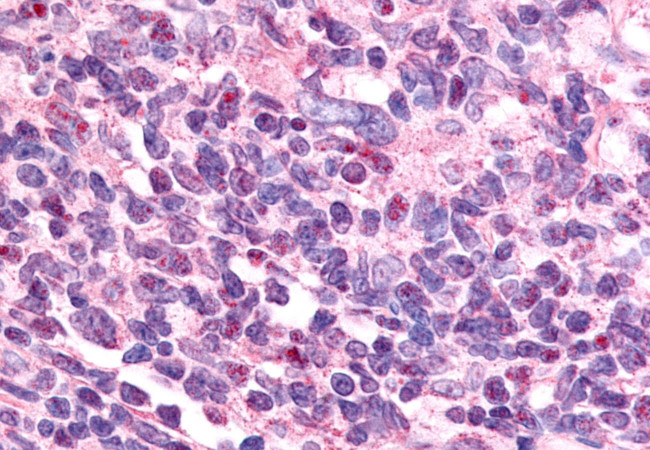
EAR2 Antibody in Immunohistochemistry (Paraffin) (IHC (P))

Search
Invitrogen
EAR2 Polyclonal Antibody
{{$productOrderCtrl.translations['antibody.pdp.commerceCard.promotion.promotions']}}
{{$productOrderCtrl.translations['antibody.pdp.commerceCard.promotion.viewpromo']}}
{{$productOrderCtrl.translations['antibody.pdp.commerceCard.promotion.promocode']}}: {{promo.promoCode}} {{promo.promoTitle}} {{promo.promoDescription}}. {{$productOrderCtrl.translations['antibody.pdp.commerceCard.promotion.learnmore']}}
产品信息
PA5-34010
种属反应
宿主/亚型
分类
类型
抗原
偶联物
形式
浓度
规格
纯化类型
保存液
内含物
保存条件
运输条件
RRID
产品详细信息
Percent identity with other species by BLAST analysis: Human, Monkey (100%) Mouse (94%) Dog (88%) Opossum (82%).
靶标信息
Transcription factor predominantly involved in transcriptional repression. Binds to promoter/enhancer response elements that contain the imperfect 5'-AGGTCA-3' direct or inverted repeats with various spacings which are also recognized by other nuclear hormone receptors. Involved in modulation of hormonal responses. Represses transcriptional activity of the lutropin-choriogonadotropic hormone receptor/LHCGR gene, the renin/REN gene and the oxytocin-neurophysin/OXT gene. Represses the triiodothyronine-dependent and -independent transcriptional activity of the thyroid hormone receptor gene in a cell type-specific manner. The corepressing function towards thyroid hormone receptor beta/THRB involves at least in part the inhibition of THRB binding to triiodothyronine response elements (TREs) by NR2F6. Inhibits NFATC transcription factor DNA binding and subsequently its transcriptional activity. Acts as transcriptional repressor of IL-17 expression in Th-17 differentiated CD4(+) T cells and may be involved in induction and/or maintenance of peripheral immunological tolerance and autoimmunity. Involved in development of forebrain circadian clock; is required early in the development of the locus coeruleus (LC).
仅用于科研。不用于诊断过程。未经明确授权不得转售。
篇参考文献 (0)
生物信息学
蛋白别名: EAR-2; Erba related 2; ERBA-related gene-2; Nuclear receptor subfamily 2 group F member 6; nuclear receptor V-erbA-related; unnamed protein product; v-erb-a avian erythroblastic leukemia viral oncogene homolog-like 2; V-erbA-related protein 2
基因别名: EAR-2; EAR2; ERBAL2; NR2F6
UniProt ID: (Human) P10588
Entrez Gene ID: (Human) 2063